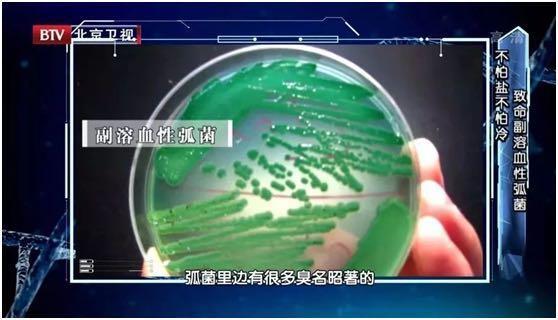

广东人外出吃饭,为啥一定要烫碗?真能消毒杀菌?怎么才能吃得安全?
2021-03-26 18:54 来源:健康罗湖

更多精彩,请点击上方蓝字关注我们!
外出食品安全问题
一直是大家心中所担忧的
很多广东人外出吃饭的时候
都习惯用开水烫碗筷、纸巾擦亦
或是直接使用一次性餐具
觉得这样更卫生
但事实真的如此吗?

烫碗、一次性碗筷靠谱吗?


开水烫碗,能灭菌?
很多人在吃饭前习惯用热水烫一下碗筷、杯子,但真的能起到杀菌消毒的作用吗?
高温的确能起到一定的杀菌消毒作用,但常规的用热水涮碗筷却达不到理想的效果。
专家表示,要达到消毒效果,至少要同时满足两个条件:①必须是100℃滚烫的开水;②不是在开水里放一下就拿起来,而是至少浸没5分钟以上。
也就是说高温消毒的两个必备条件“温度和时间”,缺一不可。


纸巾、湿纸巾擦碗,能杀菌消毒?
有些餐厅桌面上可能没有热水,也有些人比较图方便,直接用纸巾或是湿纸巾擦碗筷,这时候你可能更要担心健康隐患了~
其实餐巾纸并不一定就是干净的,尤其是一些路边餐馆的纸巾摸起来手感粗糙,若是非正规厂家生产的纸巾,可能生产过程中没有消毒杀菌的工序,用它擦碗,反而容易把大量细菌沾染到餐具上,越擦越脏!
另外,市场上还有一些湿纸巾有消毒、抑菌成分,因此有人觉得用消毒湿巾擦碗更干净。
但你可知,有消毒成分的湿纸巾,大多含有多种化学成分,并不能直接入口,用其擦碗筷反倒增加了安全隐患。


用一次性碗筷,更干净?
不少人觉得,一次性筷子还未拆封,没有使用过,应该更干净更放心一些。
但是,一方面,一次性用品过于浪费资源,不利于可持续发展;另一方面,一些餐厅的一次性餐具大多是大批量购进的,存储不当,很容易发霉。
另外,还有些小作坊在生产一次性筷子时,为了让筷子变得更白更干净,会用硫磺熏,或用双氧水浸泡,这样就不可避免地会造成一次性筷子上的二氧化硫残余量超标,进而对人体造成危害。
因此,为了避免大肠杆菌的感染,外出吃饭更建议自备碗筷。


五大常见的食源性致病菌

现在正值春夏季节交替,正是这些致病菌“猖獗”的时候,因此,要格外小心“病从口入”。

沙门氏菌

据统计,在世界各国的种类细菌性食物中毒中,沙门氏菌引起的食物中毒常列榜首!
其经常分布在肉制品、蛋制品、乳制品、蔬菜等食物当中。在7℃~45℃条件下均可生长,最适温度为35℃~37℃。因而低温储存食品是一项重要预防措施。
感染表现
潜伏期6~24小时,可有持续高热;大便为黄绿色水便,有时可带有脓血,便意频繁。若是发生在儿童身上需要特别注意,可能因急救治疗不及时导致死亡。
灭菌条件
不耐高温,55℃1小时、60℃15分钟或100℃加热数分钟即可被杀死。

金黄色葡萄球菌

蛋白质或淀粉含量丰富的食品,如乳类及乳制品、肉类、糕点、剩饭等容易感染金黄色葡萄球菌。
金黄色葡萄球菌在自然界中无处不在,空气、水、灰尘及人和动物的排泄物中都可找到。因此,食品受到污染的机会很多。

感染表现
来势凶猛,多在食后3小时内发病。吐比泻重,呕吐物中可见黄绿色胆汁,不发烧或仅有低热。多数患病者会在1~3天后康复;少数患病者可能会出现脱水、休克等严重情况。
灭菌条件
耐高温,需100℃加热2小时方能彻底灭活。另外,70%的乙醇可以在几分钟内将其快速杀死,日常可以适当用酒精喷洒。

副溶血弧菌

主要来源于鱼、虾、蟹、贝类等水产品中;含盐分较高的腌制食品,如咸菜、腌肉等也可检出。
感染表现
它可以通过消化道感染人体,引起腹痛、呕吐、腹泻等症状,腹痛以脐部阵发性绞痛为特点;也能通过血液感染人体,比如处理海鲜时不小心划破了手,细菌就可能通过伤口进入血液,破坏红细胞,引发溶血,甚至引发致死危机。
灭菌条件
50℃20分钟、65℃5分钟或80℃1分钟即可被杀死;用含1%醋酸的食醋或者1%烟酸处理5分钟也能杀灭。

肉毒杆菌

常见于肉类罐头、胀气的密封食品和发酵的豆类食品中,是最具毒性的神经毒素之一,0.1微克的肉毒杆菌便可致人死命。

感染表现
以中枢神经系统症状为主,常有头痛头晕、吞咽困难,因呼吸肌麻痹引起呼吸困难是致死的主要原因;胃肠道症状多不明显,少数病人有恶心、呕吐、腹泻等。
灭菌条件
肉毒毒素于80℃加热30分钟,就会失去活性。

李斯特菌

遇上冰箱里的低温,李斯特菌会迅速生长并繁殖,因此又被称为“冰箱杀手”!冰箱中的肉食尤其是牛肉最容易滋生李斯特菌,而后李斯特菌会污染周围食物,甚至污染整个冰箱。

感染表现
包括头痛、发热、腹泻、肌肉疼痛和疲劳等等。严重情况下,能够引起败血症、脑膜炎,甚至死亡。
灭菌条件
70℃的高温,持续2分钟便可灭活李斯特菌。

如何防止“病从口入”?

遵循世界卫生组织推荐的食品安全5要点,可有效预防大肠杆菌食物中毒等食源性疾病。
1
保持清洁
勤洗手;保持厨具餐具清洁;避免动物接触食物。
2
生熟分离
生熟食物分开放;处理生的食物用专用厨具。
3
充分做熟
肉、禽、海产彻底做熟;汤煮开;熟食再次加热要彻底。

4
保持食物的安全温度
熟食和易腐烂的食物及时冷却(5℃以下);冰箱不过久储存食物;冷冻食物不在室温下化冻。
5
使用安全的水和原材料
选择信誉好的经营场所购买食物;果蔬要洗净;不吃变质食物。

小伙伴们都记住了吗
如果觉得有用就赶快点击在看
并转发给身边的亲友吧
-End-
资料来源 | 健康时报、健康南粤、生命时报
编辑整理 | 健康罗湖
运营服务 | 晶报社
转载请注明以上信息


